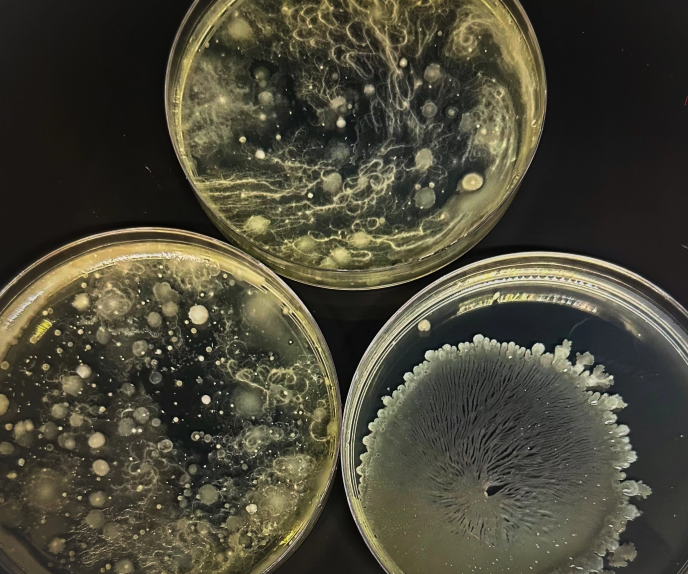
Screenshot2024-06-24at16.57.19.png

However, it is probably best to avoid reheating rice for children, pregnant women or those with a weakened immune system. Bacillus cereus infection typically results in nausea, vomiting and diarrhoea, which can cause complications in those with a compromised immune system. Most healthy adults should recover within a few days.

March 2025
To heat or not reheat, that is the question?
It is an age-old question and seems to be quite controversial when brought up during dinner table conversations – splitting the crowd like a jar of marmite.

Some are mortified at the idea of reheating rice, having heard of horror stories of people sickened by poorly stored rice, while others don’t see the point in wasting good food.
The good news is, it is generally safe to reheat cooked rice, but there are a few important guidelines you should follow to minimise any health risks, particularly from bacillus cereus, a bacterium that can ‘sometimes’ be found in rice.
This little bacteria is so feared it has even inspired its own, unique food poisoning condition known as ‘reheated rice syndrome’. Want to learn more about the pathology, symptoms, diagnosis and treatment, check out this video here.
Key Safety Tips for Reheating Rice
• Bacillus cereus spores can survive the cooking process, and if rice is left at room temperature for too long, the spores can grow into bacteria that produce toxins. To prevent this, cool the rice quickly after cooking.
• Ideally, refrigerate the rice within one hour of cooking. If it’s left out for more than two hours at room temperature, it’s best to discard it.
Store the Rice Properly
• After cooling, store the rice in an airtight container in the refrigerator. Cooked rice should be eaten within 1-2 days.
• If you want to store rice for a longer period, you can freeze it. For best results, frozen rice should be used within one month.
Reheat Thoroughly
• When reheating rice, make sure it is heated all the way through to at least 165°F (74°C). This will kill any bacteria that might have grown.
• Reheat rice either in the microwave or on the stove. If you use the microwave, add a little water to keep the rice moist, and cover it to prevent drying out. Stir the rice halfway through reheating to ensure even heat distribution.
Do Not Reheat Multiple Times
• It’s best not to reheat rice more than once. Repeated reheating increases the risk of bacterial growth and can affect the texture and taste of the rice.
Do a Sniff Test
• It is always a good idea to smell and inspect food before reheating for any signs of spoilage. If it has an unusual odour or texture, it’s better to discard it.
By following these precautions, reheating rice should be safe and should not pose any significant health risks to healthy adults.

Because bacillus cereus multiplies rapidly at room temperature and the spores can survive high cooking temperatures, for a long time, it is understandable why, some people, believe it is just not worth the risk of reheating rice. In which case, measuring your rice, to prepare the perfect amount is a good idea. We recommend 60g of uncooked rice per adult, which is roughly a full espresso cup. An easy hack is to measure 60g dry rice once, using weighing scales, and find a cup in your cupboards which closely matches the volume. In future you can simply scoop with this cup, without the need to measure again.
Want to try this filling and nutritious South Asian favourite? Check out our recipe for quick and easy Instant pot spinach dal here. This creamy, wholesome curry, made from split chickpeas, spinach and spices is packed full of flavour and goodness.